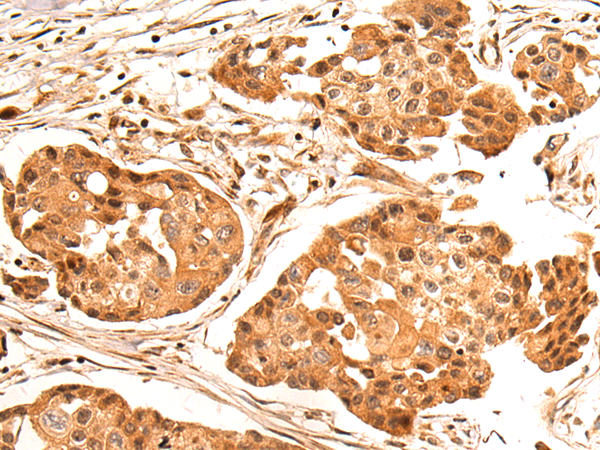
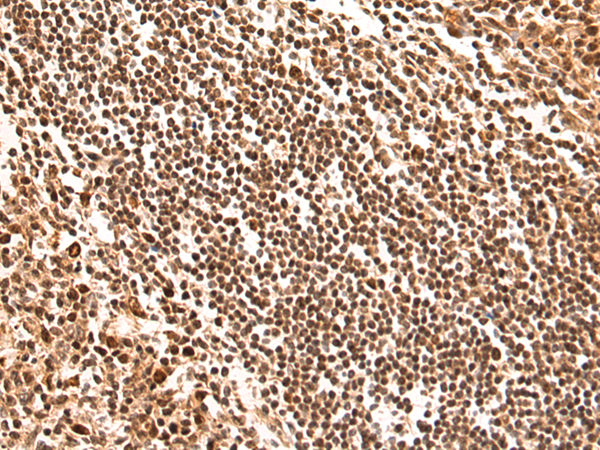
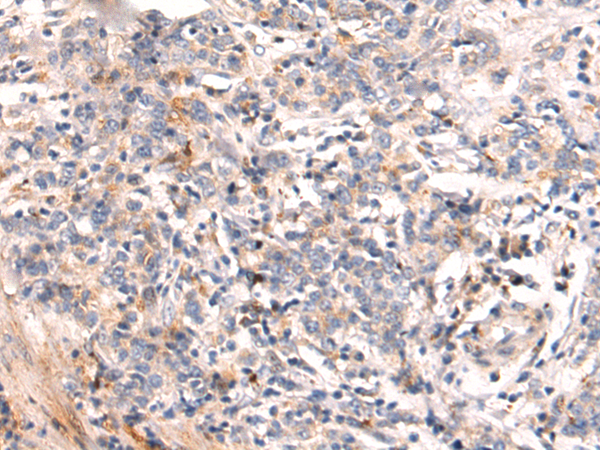

-
分类: 科研抗体货号: P10577别名:应用: WB,IHC反应种属: Human, Mouse, Rat
-
分类: 科研抗体货号: P10578别名:应用: IHC反应种属: Human, Mouse
-
分类: 科研抗体货号: P10596别名: HOP; P60; STI1; STI1L; HEL-S-94n; IEF-SSP-3521应用: WB,IHC反应种属: Human, Mouse, Rat
-
分类: 科研抗体货号: P10576别名: ORCA; CENP-33应用: WB,IHC反应种属: Human
-
分类: 科研抗体货号: P10595别名:应用: WB,IHC反应种属: Human, Mouse
-
分类: 科研抗体货号: P10574别名: KIA; MIB-; MIB-1; PPP1R105应用: IHC反应种属: Human
-
分类: 科研抗体货号: P10593别名: S7; eS7; DBA8应用: WB,IHC反应种属: Human, Mouse, Rat
-
分类: 科研抗体货号: P10572别名: ORC2L应用: WB,IHC反应种属: Human, Mouse, Rat
-
分类: 科研抗体货号: P10592别名: PMLP; TM4SF11应用: IHC反应种属: Human, Mouse, Rat
-
分类: 科研抗体货号: P10571别名: CEH; REH; TGH; ACAT; CE-1; CES2; HMSE; SES1; HMSE1; PCE-1; hCE-1应用: WB,IHC反应种属: Human

鄂公网安备42018502007531号
鄂公网安备42018502007531号

